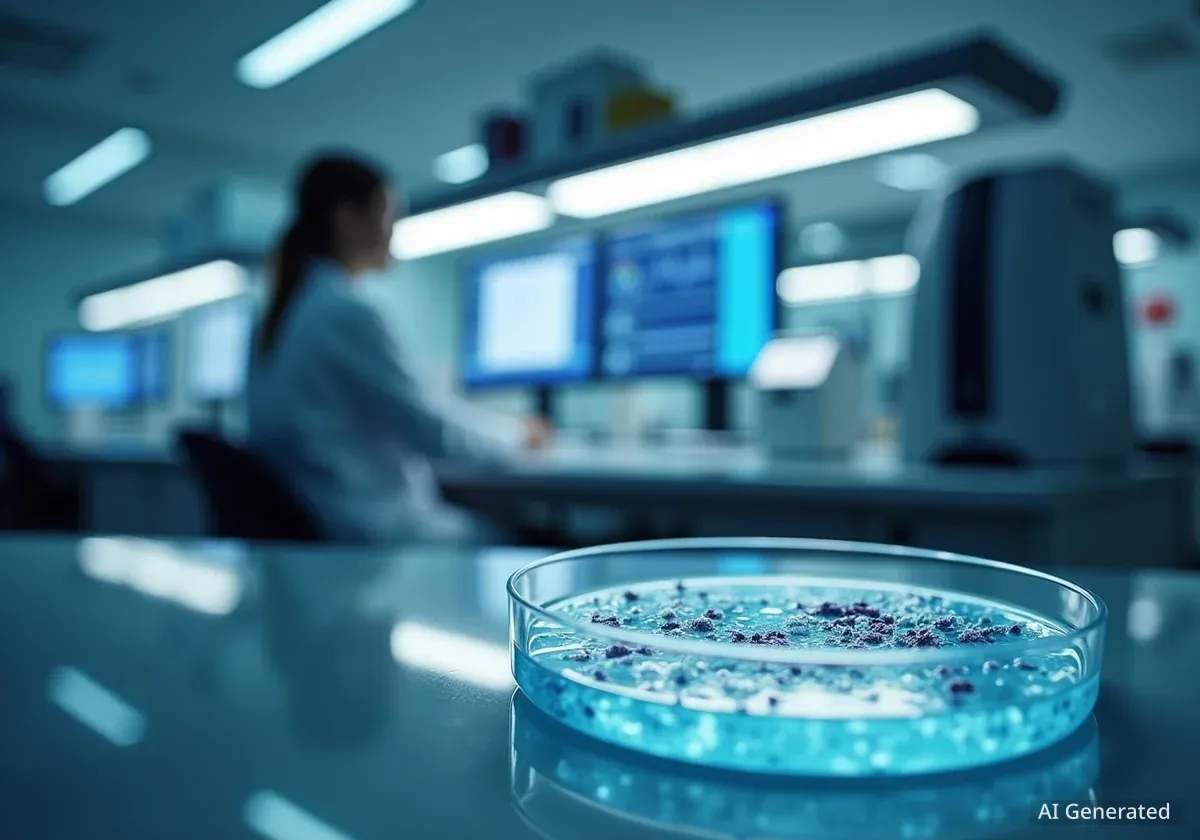
Avances en Tratamiento de Enfermedades Hepáticas

Avances en Tratamiento de Enfermedades Hepáticas
La Dra. Cristina Llorente Izquierdo lidera investigaciones cruciales sobre enfermedades hepáticas en la Universidad de California en San Diego, identificando nuevas dianas terapéuticas.
9 articles tagged
La Dra. Cristina Llorente Izquierdo lidera investigaciones cruciales sobre enfermedades hepáticas en la Universidad de California en San Diego, identificando nuevas dianas terapéuticas.

Un estudio de la Universidad de Toronto revela que casi el 25% de los adultos mayores con bienestar deficiente recuperan un estado óptimo en solo tres años, destacando la importancia de factores psico

Un estudio pionero con 15 docentes revela que cambios en nutrición, sueño y gestión emocional mejoran los niveles de estrés y bienestar sin necesidad de fármacos.

El Colegio de Médicos de Segovia celebró su evento anual en el Teatro Juan Bravo, donde premió la investigación y nombró Colegiado de Honor al Dr. Enrique Guilabert.

Investigadores del CNB-CSIC han descubierto que las toxinas de anémonas marinas podrían tener aplicaciones médicas. Su mecanismo de acción, similar al de las proteínas inmunitarias, permite perforar c

La Dra. Marta Illueca de Panamá será honrada por la Academia Americana de Pediatría en Denver, Colorado, por su labor científica, docente y teológica, y su defensa de la verdad en salud infantil.

Un estudio de la Universidad de Otago revela que la calidad del sueño es el factor más importante para el bienestar mental de los jóvenes, superando a la dieta y el ejercicio.

La Dra. Tu Youyou, Premio Nobel de Medicina, descubrió la artemisinina, un tratamiento vital contra la malaria que ha salvado millones de vidas, basándose en la medicina tradicional china. Su trabajo

James Rothman, Premio Nobel de Medicina, explica cómo su investigación reveló el principio universal de la comunicación celular, fundamental para entender la vida y las enfermedades.